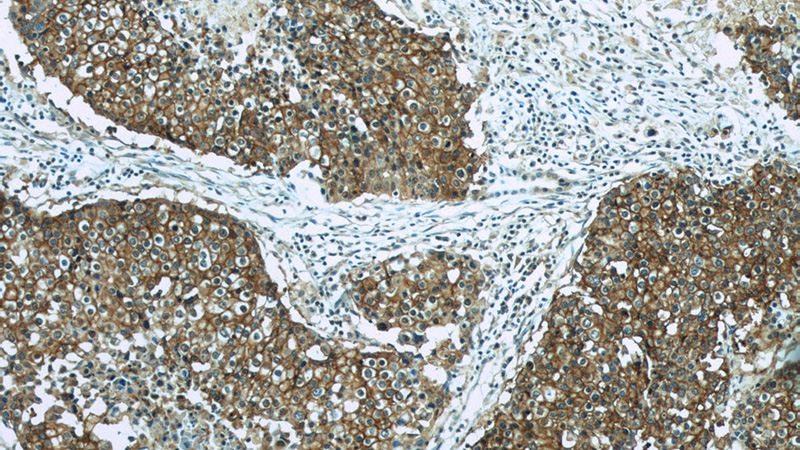
Immunohistochemistry of paraffin-embedded human lung cancer slide using Catalog No:107136(CD44 Antibody) at dilution of 1:50
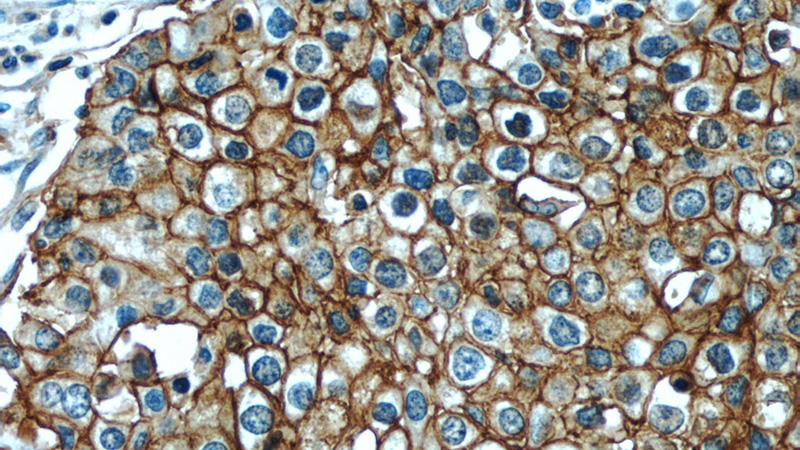
Immunohistochemistry of paraffin-embedded human lung cancer slide using Catalog No:107136(CD44 Antibody) at dilution of 1:50

-
Product Name
CD44 antibody
- Documents
-
Description
CD44 Mouse Monoclonal antibody. Positive IF detected in MCF-7 cells. Positive IHC detected in human lung cancer tissue, human tonsillitis tissue. Positive FC detected in Raji cells. Positive WB detected in Hela cells. Observed molecular weight by Western-blot: 80-95 kDa
-
Tested applications
ELISA, WB, IHC, IF, FC
-
Species reactivity
Human; other species not tested.
-
Alternative names
CD44 antibody; CD44 antigen antibody; CDW44 antibody; CSPG8 antibody; ECMR III antibody; Epican antibody; HCELL antibody; Heparan sulfate proteoglycan antibody; Hermes antigen antibody; HUTCH I antibody; Hyaluronate receptor antibody; LHR antibody; MC56 antibody; MDU2 antibody; MDU3 antibody; MIC4 antibody; MUTCH I antibody; PGP 1 antibody; PGP I antibody; Pgp1 antibody; PhagOCytic glycoprotein 1 antibody; PhagOCytic glycoprotein I antibody
-
Isotype
Mouse IgG2a
-
Preparation
This antibody was obtained by immunization of CD44 recombinant protein (Accession Number: NM_001001389). Purification method: Protein A purified.
-
Clonality
Monoclonal
-
Formulation
PBS with 0.02% sodium azide and 50% glycerol pH 7.3.
-
Storage instructions
Store at -20℃. DO NOT ALIQUOT
-
Applications
Recommended Dilution:
WB: 1:500-1:5000
IHC: 1:20-1:200
IF: 1:10-1:100
-
Validations

HeLa cells were subjected to SDS PAGE followed by western blot with Catalog No:107136(CD44 antibody) at dilution of 1:1000
Immunohistochemistry of paraffin-embedded human lung cancer slide using Catalog No:107136(CD44 Antibody) at dilution of 1:50
Immunohistochemistry of paraffin-embedded human lung cancer slide using Catalog No:107136(CD44 Antibody) at dilution of 1:50

Immunofluorescent analysis of MCF-7 cells using Catalog No:107136(CD44 Antibody) at dilution of 1:25 and Alexa Fluor 488-congugated AffiniPure Goat Anti-Mouse IgG(H+L)

1X10^6 Raji cells were stained with 0.2ug CD44 antibody (Catalog No:107136, red) and control antibody (blue). Fixed with 4% PFA blocked with 3% BSA (30 min). FITC-Goat anti-mouse IgG with dilution 1:1000.
-
Background
CD44 is a type I transmembrane glycoprotein that mediates cell-cell and cell-matrix interactions through its affinity for hyaluronic acid (HA) and possibly also through its affinity for other ligands. Adhesion with HA plays an important role in cell migration, tumor growth and progression. CD44 is also involved in lymphocyte activation, recirculation and homing, and in hematopoiesis. This protein exists in multiple isoforms generated by alternative RNA splicing and undergoes extensive post-translational modifications.
-
References
- Lu C, Huang T, Chen W, Lu H. GnRH participates in the self-renewal of A549-derived lung cancer stem-like cells through upregulation of the JNK signaling pathway. Oncology reports. 34(1):244-50. 2015.
Related Products / Services
Please note: All products are "FOR RESEARCH USE ONLY AND ARE NOT INTENDED FOR DIAGNOSTIC OR THERAPEUTIC USE"
